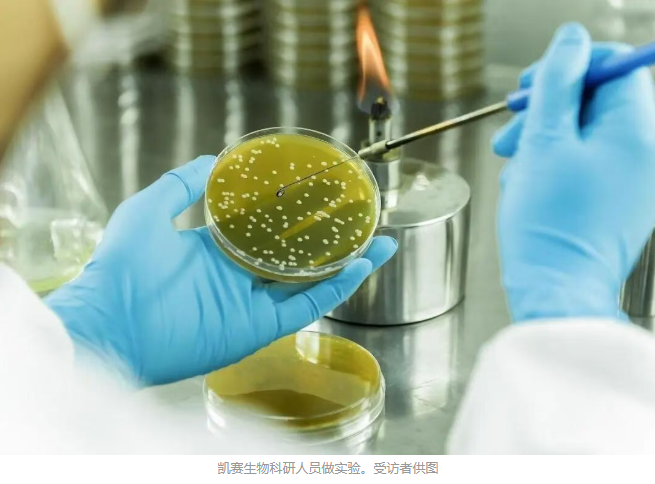
image.png

聚焦两会 | 上海:打造全国合成生物产业策源地

今年全国两会,生物制造再次成为热议的话题,这让上海儿童医学中心研究员付炜倍感兴奋。前不久,他负责的项目通过了上海市第六人民医院的伦理审查。该项目将采用modRNA(修饰信使核糖核酸)增强的间充质干细胞疗法,用于治疗严重下肢缺血患者。“目前,全球还没有一款modRNA增强细胞药物获批上市,我们团队在上海合成生物学创新中心支持下,力争实现全球首发。”付炜表示。
《中共中央关于制定国民经济和社会发展第十五个五年规划的建议》提出,推动量子科技、生物制造、氢能和核聚变能、脑机接口、具身智能、第六代移动通信等成为新的经济增长点,这些领域正是未来产业的典型代表。作为全国合成生物产业策源地,上海拥有多个“全国第一”:首个合成生物学重点实验室、首个合成生物学创新联盟、首家合成生物学上市公司上海凯赛生物技术股份有限公司(以下简称“凯赛生物”)。
面向“十五五”,上海正以基础研究筑基、制度创新护航、生态协同赋能,破解行业“死亡谷”、中试瓶颈突出等共性难题,在生物基材料、食品蛋白、生物医药等领域形成规模化突破,为全国新质生产力培育提供可复制的“上海方案”。
重塑产业发展路径
从无细胞蛋白质合成,到通过微生物发酵等技术“制造”香料、尼龙、燃料乙醇和大宗工业品……合成生物学,这门被喻为“21世纪生命科学第三次革命”的前沿学科,正以“建物致知、建物致用”的独特价值,重塑产业发展路径。通俗来讲,合成生物就是通过工程化思路改造微生物,让这些“微型工厂”高效生产医药、材料、食品等产品,甚至创造出自然界不存在的事物。
在凯赛生物研发中心一楼展厅,琳琅满目的样品勾勒出“生物质造万物”的图景:小到内衣、瑜伽服,大到储氢罐、新能源汽车配件,甚至航空温控集装箱蒙皮,都源自可再生生物质制成的生物基聚酰胺。这家成立于2000年的企业,如今已成长为全球合成生物学龙头。
类似创新的故事,同样在上海昌进生物上演。昌进生物董事长骆滨介绍,其公司的核心业务就是用微生物“酿造”蛋白。“想获得乳清蛋白,过去只能通过养牛挤奶再分离,现在用微生物72小时就能‘酿造’出来。”骆滨说,目前,昌进生物已建立从菌种筛选、菌种改造、发酵优化到蛋白分离的完整技术体系,建成1吨、5吨、45吨级生产线,与盒马合作的三蛋白脆片上市两个月即成热卖品。“公司正在研发更多新品,期望让营养健康的生物制造蛋白食品走进更多家庭。”
无细胞蛋白质合成技术,全球研究了70余年、相关文献数十万篇,技术却难以走出实验室,如今在上海成为现实。“如果把生物药比作芯片,无细胞蛋白质合成反应器就是下一代制造生物药的‘光刻机’。”康码(上海)生物科技有限公司(以下简称“康码生物”)创始人郭敏形象比喻。
这家成立于2015年的企业发展速度惊人:2020年,完成世界首条5吨级D2P蛋白质工厂生产线;2023年,生产线的批次规模提升至160吨级;如今,利用这条无细胞蛋白质合成领域全球唯一实现百吨级以上量产的生产线,康码生物已开发下游产品超30款,且大规模上市,打通了商业化闭环。
硅羿科技(上海)则通过合成生物制造技术,全链路构建RNA农药研发到生产工艺体系。“我们已把双链RNA的生产成本降到每克1美元以下。很难想象,十年前一克需要1万美元。”公司创始人唐雪明说,2024年,RNA农药技术入选《科学》杂志评选的全球十大科学突破,目前该公司多条管线正在推进产品登记。
截至2025年底,上海合成生物核心企业已超40家,数量位居全国第一;上下游企业数量约占全国30%,核心专利数突破千项。
工作人员进行生物合成实验。受访者供图
破解成果转化难题
作为颠覆性的科学突破和技术创新领域,如果说研发是合成生物学产业化的起点,那么,产业化放大和工艺工程则是决定其落地成败的最后硬仗。“合成生物学产业化的关键是跨越‘死亡谷’,即要形成为市场认可、满足市场需求的产品。”中国科学院院士赵国屏说。他在多个场合公开演讲称,即便跨过“死亡谷”,产品还需经历工程转化、工艺中试、临床研究等“上甘岭”式考验。
基础研究的深厚积淀,为产业发展筑牢根基。2008年,我国首个合成生物学实验室——中国科学院分子植物科学卓越创新中心合成生物学重点实验室(以下简称“实验室”)成立。作为我国“建制性研究”的最初尝试,实验室已培育出一批顶尖科研力量。例如,实验室研究员覃重军带领团队在国际上首次将真核生物酿酒酵母天然的16条染色体人工合成为有功能的单条巨大染色体,实现了“人造生命”里程碑式重大突破。该成果入选2018年度中国科学十大进展。
为跨越从实验室到生产线的“达尔文死海”,上海着力构建“平台+资本”双轮驱动的赋能生态。2023年11月成立的上海合成生物学创新中心,创新推出“项目经理人制+虚拟公司”模式,6位名校博士组成的项目经理人团队,正在推进10余个概念验证项目。
上海合成生物学创新中心执行主任付小龙介绍,在上海市科委支持下,创新中心为每个概念验证项目提供100多万元经费,并注册“虚拟公司”开展中试工艺放大、市场需求验证等工作。如果概念验证成功,公司将启动天使轮融资,蜕变成一家真正的科技企业;如果概念验证失败,就注销公司,可有效降低科研人员创业风险。负责modRNA增强细胞疗法项目的项目经理人谢俊东表示:“我们的任务就是整合资源,让实验室成果更快走向市场。”
补齐中试转化短板让产业落地加速。一批国家级平台持续提升能级,为创新提供坚实的公共实验与中试转化支撑。合创绿洲入选工业和信息化部首批生物制造中试能力建设平台,生合万物与上海化工区合作建设天然产物合成生物制造示范线,可将实验室克级产物提升至百公斤级量产规模,目前已启动稀有人参皂苷、麦角硫因等产品的工程验证。
上海中创产业创新研究院区域经济研究中心主任、高级研究员蒋英杰认为,面向“十五五”,上海还需要围绕资源共享、成果转化、资本协同、人才共育形成常态化机制,以生态赋能,加快形成由平台与资本编织的创新“热带雨林”。
资本赋能让创新活力持续迸发。2025年10月,总规模10亿元的上海首个生物制造产业基金启动,采用“C(产业链主企业)+VC(专业投资机构)”模式,将形成从概念验证到产业化的资金支持闭环。“我们与上海合成生物学创新中心合作,从最早挖掘项目到后续资源导入,每一步都能看到基金深度参与的影子。”上海未来产业基金总经理魏凡杰说。
“十五五”续写新篇章
作为产业策源地,上海合成生物产业已形成从基础研究到技术转化的完整创新链。
“上海能在全国保持领先,核心源于四大优势:原始创新能力强、产业基础好、国际化优势突出、资本集聚效应显著。”付小龙分析说。上海作为引领合成生物产业变革的核心枢纽,集聚了上海交通大学、复旦大学、中国科学院下属研究所等众多高校院所,依托长三角区域发达的生物医药产业形成了完善的产业配套体系,凭借国际化的营商环境吸引着全球创新资源,最终将多重先发优势转化为从原始创新到产业落地的 “高速通道”。
系统完善的政策体系为产业发展保驾护航。2023年,上海出台《上海市加快合成生物创新策源 打造高端生物制造产业集群行动方案(2023—2025年)》。记者从上海市相关部门获悉,目前正在编制的《上海市加快推进新型工业化 构建现代化产业体系“十五五”规划》中明确,“十五五”期间,上海生物制造产业将塑造“1+5”核心创新能力,即“AI+”微生物智能化开发制造系统,非粮生物基原料高效利用、无机碳源生物转化技术、底盘细胞创制、酶催化低成本路径设计、颠覆性生物反应器五大共性技术,目标到2030年,力争生物制造产品产值翻番,带动应用产值超千亿元。
面向“十五五”,上海当前已形成“科研—产业—政策”多维联动、多区协同的体系化布局,通过浦东、闵行、宝山、金山等重点区特色载体建设,吸引生物科技、生物制造等领域企业及科研团队入驻,打造全球生物经济创新策源地和产业高地。“围绕‘全球创新药械首发地、科学家创新创业首选地、制度改革突破首创地’目标,浦东将实施‘创新筑基、集群培育、加速成果转化、产业护航、生态提升’等行动,为合成生物学转化贡献‘浦东力量’。”浦东新区副区长徐徕表示。
“‘十五五’期间,上海的发展重点不是在个别赛道追求单点突破,而是要努力建设一座能提供可复制经验的创新之城。”上海合成生物学创新中心理事长金勤献介绍,“我们正主动对接全球科研网络,和国际伙伴深化技术合作。眼下整个产业都在加速奔跑,我们也正牵头整合各方资源,朝着打造国内领先、国际一流的合成生物产业集群全力迈进。”


▌参考信息:本文部分素材来自***。由作者重新编写,系作者个人观点,本平台发布仅为了传达一种不同观点,不代表对该观点赞同或支持。如果有任何问题,请联系我们:15356747796(微信同号)。
